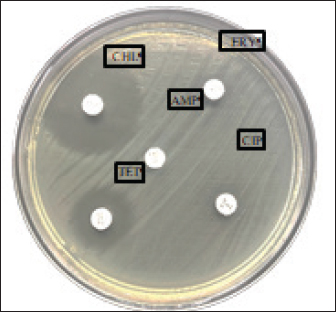
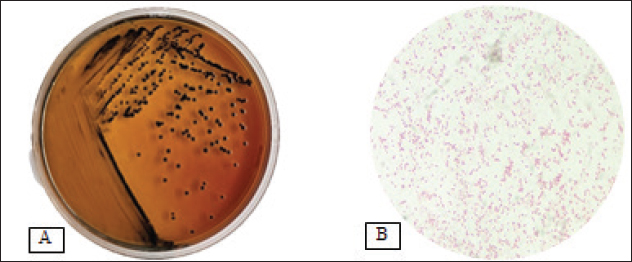

| Research Article | ||
Open Vet. J.. 2025; 15(6): 2661-2670 Open Veterinary Journal, (2025), Vol. 15(6): 2661-2670 Research Article Detection of the mgtC gene in multidrug-resistant Salmonella sp. based on isolation of chicken eggshell swabs from traditional Surabaya marketsLeonardo Reza Srimaryanto1, Wiwiek Tyasningsih2*, Azhari Athaillah Sulaiman1, Budiastuti Budiastuti3, Aswin Rafif Khairullah4, Mustofa Helmi Effendi5, Pitaloka Kurniasari1, Agus Widodo6, Sheila Marty Yanestria7, Ikechukwu Benjamin Moses8, Riza Zainuddin Ahmad4, Katty Hendriana Priscilia Riwu9, Daniah Ashri Afnani1,0 and Saifur Rehman11,11Master Program in Veterinary Science and Public Health, Faculty of Veterinary Medicine, Universitas Airlangga, Surabaya, Indonesia 2Division of Veterinary Microbiology, Faculty of Veterinary Medicine, Universitas Airlangga, Surabaya, Indonesia 3Study Program of Pharmacy Science, Faculty of Health Science, Universitas Muhammadiyah Surabaya, Surabaya, Indonesia 4Research Center for Veterinary Science, National Research and Innovation Agency (BRIN), Bogor, Indonesia 5Division of Veterinary Public Health, Faculty of Veterinary Medicine, Universitas Airlangga, Surabaya, Indonesia 6Department of Health, Faculty of Vocational Studies, Universitas Airlangga, Surabaya, Indonesia 7Faculty of Veterinary Medicine, Universitas Wijaya Kusuma Surabaya, Surabaya, Indonesia 8Department of Applied Microbiology, Faculty of Science, Ebonyi State University, Abakaliki, Nigeria 9Department of Veterinary Public Health, Faculty of Veterinary Medicine, Universitas Pendidikan Mandalika, Mataram, Indonesia 10Department of Microbiology and Parasitology, Faculty of Veterinary Medicine, Universitas Pendidikan Mandalika, Mataram, Indonesia 11Department of Pathobiology, Faculty of Veterinary and Animal Sciences, Gomal University, Dera Ismail Khan, Pakistan * Corresponding Author: Wiwiek Tyasningsih. Division of Veterinary Microbiology, Faculty of Veterinary Medicine, Universitas Airlangga, Surabaya, Indonesia. Email: wiwiek-t [at] fkh.unair.ac.id Submitted: 23/02/2025 Revised: 21/04/2025 Accepted: 01/05/2025 Published: 30/06/2025 © 2025 Open Veterinary Journal
AbstractBackground: The virulence of Salmonella sp. is increased by the presence of the mgtC gene, which allows the bacteria to survive in environments with low magnesium levels, such as inside macrophages. Salmonella sp. found on eggshells when they show resistance to three or more classes of antibiotics can be classified as multidrug-resistant (MDR) bacteria. Aim: This study aimed to identify the presence of Salmonella sp. MDR and the mgtC gene in chicken eggshell swabs from traditional markets in Surabaya. Methods: Swab samples were collected from 160 eggs (80 from layer chickens and 80 from free-range chickens) at 10 traditional markets in Surabaya, Indonesia. Isolation and identification were performed using culture media, including Salmonella Shigella Agar, Gram staining, Triple Sugar Iron Agar, Sulfide Indole Motility, Simmons Citrate Agar, Methyl Red and Voges Proskauer, and Urea Agar. Antibiotic sensitivity testing was performed using the disc diffusion method on Mueller–Hinton Agar. Molecular detection of the mgtC gene was performed using polymerase chain reaction. Results: The results showed that 16.87% (27/160) of the samples were detected positive for Salmonella sp. All Salmonella sp. isolates (27) were resistant to Erythromycin (100%). Resistance was also found to Ampicillin (77.77%, 21/27), Tetracycline (29.62%, 8/27), and Ciprofloxacin (18.51%, 5/27). No resistance to chloramphenicol was observed. In addition, eight of the 27 isolates (29.62%) were classified as Salmonella sp. MDR. The Salmonella sp. MDR isolates also carried the mgtC gene at 87.5% (7/8). Conclusion: These findings demonstrate the potential global public health threat posed by MDR Salmonella sp. with the mgtC gene, emphasizing the importance of monitoring and controlling antibiotic resistance in humans and animals. Keywords: Eggs, MDR, mgtC, Public health, Salmonella sp.. IntroductionSalmonella sp. is a Gram-negative, pathogenic bacteria and is the most common foodborne disease-causing agent found worldwide (Lamichhane et al., 2024). Salmonella sp. can cause salmonellosis, a zoonotic disease that attacks the digestive tract with a high rate of transmission to animals and humans (Galán-Relaño et al., 2023). The virulence factor in Salmonella sp. is one of the causes of the high incidence of salmonellosis because it allows these bacteria to survive in an unsupportive environment and cause infection (Yulian et al., 2020). One of the important virulence factors of Salmonella pathogenicity island 3 is the gene encoding mgtC (Choi et al., 2019). This gene is commonly found in certain Salmonella serotypes, especially those with higher pathogenic potential, such as Salmonella enterica, which can cause infections in humans and animals. The transfer of the mgtC gene can occur through horizontal gene transfer (HGT) mechanisms. Moreover, the mgtC gene can also be passed on through vertical gene transfer during bacterial cell division. However, HGT is more commonly involved in the spread of this gene among different strains or species of Salmonella (Andesfha et al., 2019). The mgtC gene plays an important role in the production of the mgtC protein, which functions to bind the F F types of antibiotics, which are categorized as multidrug resistant (MDR). According to Marchello et al. (2020), 32.6% (1,638/5,032) of Salmonella typhi isolates from Asia during 2015–2018 have been identified as MDR. Eggs are a livestock product that plays an important role as a source of animal protein for humans (Puglisi and Fernandez, 2022). In addition to having high nutritional content, eggs are also popular because of their delicious taste and can be processed into various types of food (Réhault-Godbert et al., 2019). Eggs that are commonly consumed come from layer chickens and native chickens. Layer chicken eggs are easier to find in traditional markets because their production is higher and more stable than that of native chicken (Mir et al., 2017). However, both layer and native chicken eggs sold in traditional markets are often susceptible to contamination (Rouger et al., 2017). Traditional markets, including those in Surabaya, often have inadequate sanitation, making them an ideal environment for the growth and spread of various pathogens (Putri et al., 2024). Poor hygiene, a high number of visitors, and uncontrolled environmental conditions can increase the risk of contamination with food products, including eggs from native and layer chickens (Kendek et al., 2024). These eggs can easily be exposed to bacteria from dust, soil, or unhygienic water, as well as from the hands of sellers or unclean 10 equipment (Mkangara, 2023). Unhygienic conditions ATP synthase enzyme. By binding to this enzyme, mgtC can reduce the influx of H+ ions into the cell, thereby helping the bacteria maintain ATP levels even when intracellular magnesium (Mg²+) concentrations are low (Lee et al., 2013). The presence of mgtC protein enables the bacteria to survive and replicate at low levels within phagocytic cells (Groisman et al., 2013). Without mgtC, Salmonella cannot survive in the stressful intracellular environment of low Mg²+ levels. Salmonella sp. carrying the mgtC virulence gene tends to be more resistant to intracellular stress, allowing them to survive and reproduce in macrophages, where they should function to kill pathogens (Garai et al., 2012). In addition to virulence factors, antibiotic resistance also plays a role in the increased number of Salmonella sp. infection cases. The significance of Salmonella sp. is also related to public health issues arising from antibiotic-resistant isolates (antimicrobial resistance) in both veterinary and human medicine (Siriken et al., 2020). According to Gach et al. (2024), Southeast Asia is one of the regions with the highest levels of antibiotic resistance in the world, with Indonesia ranking eighth out of 27 countries with a high burden of antibiotic resistance. Salmonella sp. isolates found on eggshells have shown resistance to antibiotics, and Salmonella sp. isolates also resistant to multiple antibiotics have been detected in chicken eggs in various countries (Castro-Vargas et al., 2020; Hai et al., 2020; Archer et al., 2023 et al. et al.). Based on a study by Pławińska-Czarnak et al. (2023), Salmonella sp. is resistant to three or more in traditional markets can support the development of pathogenic bacteria such as Salmonella sp. (Alegbeleye et al., 2018). These bacteria can move from eggshells to food products, increasing the risk of infection in consumers (Whiley and Ross, 2015). Salmonella sp. contamination in eggs with feces- exposed shells is higher than that in shells that are clean from feces (Jibril et al., 2020). Salmonella sp. can also survive and grow on eggshell surfaces at low temperatures. Salmonella sp. was detected on eggshells during the rainy season when high humidity levels supported their growth and survival (Olabode et al., 2020). Salmonella sp. contamination of eggshells can also spread to the white and yolk because these bacteria are capable of penetrating through the pores of the eggshell (Momani et al., 2018). The presence of the mgtC gene in Salmonella sp., which is resistant to various types of antibiotics is a serious threat to global public health. The ability of this bacteria to evade the immune system and its resistance to various classes of antibiotics can increase the risk of spreading infections in humans and animals (Kurtz et al., 2017). This condition contributes to the increased incidence of diseases caused by Salmonella sp. (Long et al., 2017). Reports on Salmonella sp. MDR that express the mgtC gene in chicken eggshells in Indonesia are limited. Therefore, research on Salmonella isolation, MDR, and the presence of the mgtC gene in chicken eggshells is required. This study aimed to identify the mgtC virulence gene of Salmonella sp. MDR in Indonesia. Hopefully, our findings regarding this virulence factor will increase public awareness of egg food safety and provide further understanding of salmonellosis. Materials and MethodsResearch designThis study is exploratory research conducted in a laboratory using an observational design to observe the phenomena that occur and was conducted from December 2024 to January 2025. Sampling was carried out in traditional markets in five areas in Surabaya, Indonesia. Isolation, identification, and antibiotic sensitivity testing were performed at the Veterinary Public Health Laboratory, Faculty of Veterinary Medicine, Airlangga University. Detection of the mgtC gene by Polymerase Chain Reaction (PCR) test was carried out at the Institute of Tropical Disease, Airlangga University, Surabaya. Sample collectionThe samples consisted of 160 eggshell swabs (80 from layer chickens and 80 from native chickens) collected from traditional markets in Surabaya, Indonesia in five areas: West Surabaya (Simo and Sememi Markets), East Surabaya (Manyar and Pucang Markets), North Surabaya (Kapas Krampung and Pabean Markets), South Surabaya (Wonokromo and Wiyung Markets), and Central Surabaya (Keputran and Pacar Keling Markets). Sampling was performed using sterile cotton swabs on the surface of chicken eggshells. Each swab was placed in sample pots containing 5 ml of 1% Buffered Peptone Water (BPW) and labeled (Pradika et al., 2019). Furthermore, 1 ml of the BPW sample was transferred into 10 ml of Tetrathionate Broth enrichment media and incubated for 24 hours at 37°C (Putri et al., 2023). Isolation and Identification of Salmonella spp.Salmonella sp. were isolated using Salmonella Shigella Agar (SSA) media and incubated for 24 hours at 37°C. For each Salmonella-like colony, morphological identification was carried out using Gram staining, followed by biochemical tests using media such as Triple Sugar Iron Agar, Simmons Citrate Agar, Urea Agar, and IMVIC tests, namely Sulfide Indole Motility, Methyl Red, and Voges Proskauer (VP) (Effendi et al., 2018). Antibiotic sensitivity testThe antibiotic discs used included five classes of antibiotics: Ampicillin 10 µg (Oxoid, UK), Tetracycline 30 µg (Oxoid, UK), Ciprofloxacin 5 µg (Oxoid, UK), Chloramphenicol 30 µg (Oxoid, UK), and Erythromycin 15 µg (Oxoid, UK), in accordance with the guidelines of the Clinical and Laboratory Standards Institute (CLSI). Antibiotic sensitivity testing was performed using the Kirby–Bauer disc diffusion method on MHA media (Fanissa et al., 2022). Bacterial colonies from SSA media were transferred to sterile tubes containing physiological NaCl solution with a McFarland standard of 0.5 (1–2 x 108 CFU/ml) (Effendi et al., 2018). The bacterial culture was evenly distributed on an MHA medium in a Petri dish divided into five parts. Antibiotic discs were placed on the media and incubated at 37 °C for 24 hours. The results were analyzed by measuring the diameter of the inhibition zone according to the CLSI (CLSI, 2023). Salmonella sp. isolates are categorized as MDR if the bacteria are resistant to three or more classes of antibiotics. Molecular detection of the mgtC gene using PCRDetection of the mgtC gene can be done using PCR using specific primers: forward: TGACTATCAATGCTCCAGTGAAT and reverse: ATTTACTGGCCGCTATGCTGTTG with a target product length of 655 bp (Andesfha et al., 2019). DNA amplification was carried out using ready-to- use reagent GoTag® Green Mastermix (Promega, 2018), with the following cycle: pre-denaturation at 95°C for 15 minutes, followed by 30 cycles including denaturation at 94°C for 1 minute, annealing at 60°C for 1 minute, and extension at 72°C for 1 minute, ending with a final extension at 72°C for 10 minutes (Andesfha et al., 2019). Ethical approvalNot needed for this study. ResultThe results of the isolation and identification of Salmonella sp. bacteria showed that 27 samples (16.87%) were positive for the bacteria. A total of 15 samples came from layer eggshells (18.75%), while the others came from 12 samples from native chicken eggshells (15%). Based on the results of the isolation and identification of Salmonella sp. from chicken eggshell swabs in traditional markets in Surabaya, it was revealed that Simo Market had the highest prevalence of Salmonella sp., reaching 43.75% (7/16) (Table 1). Macroscopic observation of Salmonella sp. growing on SSA media showed bacterial colonies that were round, convex, smooth-textured, shiny, flat edges, and black in the middle. The results of microscopic examination with Gram staining revealed the morphology of Salmonella sp. in the form of straight red rods (Fig. 1). The antibiotic resistance test against Salmonella sp. using five antibiotic groups (Fig. 2) showed that the highest incidence occurred with erythromycin antibiotics at a percentage of 100% (27/27), and none of the isolates showed resistance to chloramphenicol (Table 2). The incidence of Salmonella sp. resistant to various antibiotic groups in traditional markets in Surabaya was 8 isolates (29.62%). The percentage of MDR Salmonella sp. from several traditional Surabaya markets showed varying results. Wiyung Market was recorded as having the highest MDR incidence at a percentage of 100% (1/1). No MDR cases were found in the Sememi, Pucang, Keputran, and Pacar Keling markets (Table 3). Table 1. Isolation and identification of Salmonella sp.
The results of resistance based on antibiotic sensitivity tests provide an interpretation of MDR in Salmonella sp. isolates with AMP/ERY/TET resistance patterns of three isolates (37.5%), AMP/ERY/CIP resistance patterns of two isolates (28.57%), ERY/TET/CIP resistance patterns of two isolates (28.57%), and AMP/ERY/TET/CIP resistance patterns of one isolate (14.28%) (Table 4). The results of this study indicate that of the eight isolates of Salmonella sp. MDR, seven isolates (87.5%) showed a positive band at 655 bp, indicating that the isolates had the mgtC gene (Fig. 3). DiscussionSalmonella sp. contamination of eggs is not only environmental contamination but can also be transmitted from layer chickens infected with Salmonella (Shaji et al., 2023). Salmonella sp. can infect layer and native chickens through the environment, feeding, drinking water, and contact with infected animals or humans (Lamichhane et al., 2024). Commercial farms are at high risk because of population density, which accelerates the spread of bacteria (Neelawala et al., 2024). Contamination can also come from feed and drinking water during production or distribution (Shaji et al., 2023). Transportation and environmental stress can weaken layer chicken immunity and increase the risk of infection (Abo-Al-Ela et al., 2021). Native chickens are also susceptible to they often roam in open areas and are exposed to bacteria from soil, water, or other animal feces. Feed that is not guaranteed to be clean also increases the risk of contamination (McMullin, 2022). Salmonella sp. contamination of eggshells in traditional markets in Surabaya is influenced by poor AMP = Ampicillin, ERY = Erythromycin, CIP = Ciprofloxacin, TET = Tetracycline, CHL = Chloramphenicol, R = Resistant. sanitation hygiene, dirty market environments, and improper transportation and storage (Mkangara, 2023). The results of the isolation and identification of Salmonella sp. bacteria showed that 27 out of 160 swab samples of eggshells of layer chickens (15) and native chickens (12) from the Surabaya traditional market were positive for Salmonella sp. (16.87%). Previous research showed that Salmonella sp. contamination at the Wage Market in Purwokerto was lower at 3.33% (1/30) (Wahyuningsih et al., 2019). This indicates that the presence of Salmonella sp. on eggshells is a significant problem that requires attention and appropriate handling measures (Perry and Yousef, 2012).
Fig. 2. Multidrug resistant in Salmonella sp. Description: AMP=Ampicillin, ERY = Erythromycin, CIP = Ciprofloxacin, TET = Tetracycline, CHL = Chloramphenicol.
Fig. 1. (A) Salmonella sp. colony on SSA media. (B) Salmonella sp. morphology, showing a red color with a straight rod shape. Table 2. Antibiotic resistance in layer eggshells and native chickens.
The results of the resistance test showed that Salmonella sp. 100% (27/27) were resistant to Erythromycin. The study by Maharjan et al. (2021) also reported that all Salmonella sp. isolates experienced decreased sensitivity to this antibiotic. Isolates from chicken farms in Cianjur were also recorded as being 100% resistant. This indicates that erythromycin is no longer effective in controlling Salmonella sp. infection (Nair et al., 2018). This high resistance is attributed to mutations or horizontal transfer of resistance genes originating from the farm environment that spread to traditional markets (Oladeinde et al., 2021). Salmonella sp. resistance to Ampicillin in this study reached 77.77% (21/27), in line with the report by Gil-Molino et al. (2022) of 75%. Resistance of Gram-negative bacteria to the antibiotic ampicillin occurs through the production of beta-lactamase enzymes, which break the beta- lactam ring, thereby rendering its antibacterial activity ineffective. This enzyme opens the beta-lactam ring of ampicillin and eliminates its antimicrobial activity (Widodo et al., 2023). The resistance test results for tetracycline antibiotics in this study were 29.62% (8/27). The occurrence of Tetracycline antibiotic resistance in Salmonella sp. was previously reported by Syafitri et al. (2023) at a rate of 87.5%. The most common mechanism underlying bacterial resistance to tetracycline is the efflux pump resistance mechanism (Chopra and Roberts, 2001). Resistance to ciprofloxacin in this study was 18.51% (5/27). Wibisono et al. (2021) previously reported a 46% resistance rate of Salmonella sp. to ciprofloxacin. This is due to the routine use of fluoroquinolone antibiotics by farmers (Manyi-Loh et al., 2018). Resistance to chloramphenicol was not observed in this study. However, Islam et al. (2022) reported chloramphenicol resistance in Salmonella sp. at 41.66%. The excessive and irrational use of chloramphenicol can trigger bacterial resistance (Mancuso et al., 2021). Table 3. Identification of MDR antibiotics against Salmonella sp. Bacteria.
Table 4. The resistance pattern of MDR Salmonella sp.
Fig. 3. PCR results of mgtC gene in Salmonella sp. isolates that are MDR. Lane M=DNA marker 100 bp ladder, lane NC=Nuclease free water as a negative control, lane NWSI-7, KSI-5, NEM-8, KWSI-8, NNP-2, KNK-5, NWSI-2. positive result of mgtC gene and NSW-8 negative result of mgtC gene. Antibiotics that continue to experience resistance will trigger the emergence of MDR, in which bacteria experience resistance to three or more different antibiotic classes (Khairullah et al., 2019; Ramandinianto et al., 2020; Widodo et al., 2022). A total of 8 Salmonella sp. isolates in this study showed multidrug-resistant (MDR) properties of 29.62% (8/27). Other studies were reported by Soria et al. (2024) in egg samples from Argentina that experienced MDR against Salmonella sp. by 87%. The occurrence of resistance can vary in different regions. These differences may be attributable to variations in the environment and the level of antibiotic use in those areas (Tao et al., 2017). The routine use of broad-spectrum antibiotics is also a factor contributing to changes in resistance patterns to various types of antibiotics (Khairullah et al., 2024). Antibiotic sensitivity tests showed that Salmonella sp. isolates from eggshell swabs from traditional markets in Surabaya had a MDR pattern with various antibiotic combinations. Bacterial resistance patterns can vary in each region due to differences in the environment and levels of antibiotic use (Tao et al., 2017). The routine use of broad-spectrum antibiotics also contributes to changes in resistance patterns (Khairullah et al., 2023). PCR test showed that the mgtC gene was detected in seven of eight isolates that were considered MDR (87.5%). Previous studies reported that the mgtC gene was detected in Salmonella sp. isolates at a percentage of 100% (27 / 27) (Andesfha et al., 2019). The presence of the mgtC gene in Salmonella sp., which is multidrug resistant, poses a serious threat to global public health. The ability of this bacteria to evade the immune system and confer resistance to various classes of antibiotics increases the risk of spreading infections to humans and animals (Billah and Rahman, 2024). This condition contributes to the increased incidence of diseases caused by Salmonella sp. ConclusionThis study found Salmonella sp. in 27 of 160 isolates (16.87%) of chicken eggshells in Surabaya Traditional Market, with eight isolates (29.62%) being MDR. The mgtC gene was detected in seven of eight MDR isolates (87.5%). Increasing public awareness of food safety and farmers’ understanding of Salmonellosis is very important. Prevention and control of multidrug resistance can be achieved through the wise use of antibiotics. This study provides descriptive insights into the phenomenon observed in the sample but does not use statistical analysis to test the significance of differences or relationships between variables. Therefore, the results should be considered as useful preliminary findings. However, it is important to note that generalizing these findings to a broader population requires further research with a more in-depth statistical approach. AcknowledgmentsThe authors would like to thank the Universitas Airlangga. Conflict of interestThe authors declare no conflict of interest. FundingThis study was partly supported by The International Research Consortium, Lembaga Penelitian dan Pengabdian Masyarakat, Universitas Airlangga, Surabaya, Indonesia in the year 2024 with grant number: 171/UN3.LPPM/PT.01.03/2024. Author’s contributionsLRS, AAS, and ARK: Conceived, designed, and coordinated the study. WT, PK, and MHE: Designed data collection tools, supervised the field sample and data collection, and laboratory work as well as data entry. KHPR, IBM, and SR: Validation, supervision, and formal analysis. AW, SMY, and BB: Contributed reagents, materials, and analysis tools. DAA and RZA: Statistical analysis and interpretation and preparation of the manuscript. All authors have read, reviewed, and approved the final manuscript. Data availabilityAll data are available in the manuscript. ReferencesAbo-Al-Ela, H.G., El-Kassas, S., El-Naggar, K., Abdo, S.E., Jahejo, A.R. and Al Wakeel, R.A. 2021. Stress and immunity in poultry: light management and nanotechnology as effective immune enhancers to fight stress. Cell Stress Chaperones 26(3), 457–472. Alegbeleye, O.O., Singleton, I. and Sant’Ana, A.S. 2018. Sources and contamination routes of microbial pathogens to fresh produce during field cultivation: A review. Food Microbiol. 73(1), 177–208. Andesfha, E., Indrawati, A., Mayasari, N.L.P.I., Rahayuningtyas, I. and Jusa, I. 2019. Detection of Salmonella pathogenicity island and Salmonella plasmid virulence genes in Salmonella Enteritidis originated from layer and broiler farms in Java Island. J. Adv. Vet. Anim. Res. 6(3), 384–393 Archer, E.W., Chisnall, T., Tano-Debrah, K., Card, R.M., Duodu, S. and Kunadu, A.P. 2023. Prevalence and genomic characterization of Salmonella isolates from commercial chicken eggs retailed in traditional markets in Ghana. Front. Microbiol. 14(1), 1283835. Billah, M.M. and Rahman, M.D.S. 2024. Salmonella in the environment: a review on ecology, antimicrobial resistance, seafood contaminations, and human health implications. J. Hazard Mater. Adv. 13(1), 100407. Castro-Vargas, R.E., Herrera-Sánchez, M.P., Rodríguez-Hernández, R. and Rondón-Barragán, I.S. 2020. Antibiotic resistance in Salmonella spp. isolated from poultry: a global overview. Vet. World 13(10), 2070–2084. Choi, S., Choi, E., Cho, Y.J., Nam, D., Lee, J. and Lee, E.J. 2019. The Salmonella virulence protein MgtC promotes phosphate uptake inside macrophages. Nat. Commun. 10(1), 3326. Chopra, I. and Roberts, M. 2001. Tetracycline antibiotics: mode of action, applications, molecular biology, and epidemiology of bacterial resistance. Microbiol. Mol. Biol. Rev. 65(2), 232–260. CLSI (Clinical and Laboratory Standards Institute). 2023. Performance standards for antimicrobial susceptibility testing. 33rd. ed. CLSI supplement M100. Wayne, PA: Clinical and Laboratory Standards Institute. Effendi, M.H., Harijani, N., Yanestria, S.M. and Hastutiek, P. 2018. Identification of Shiga toxin- producing Escherichia coli in raw milk samples from dairy cows in Surabaya, Indonesia. Philipp. J. Vet. Med. 55(SI), 109–114. Fanissa, F., Effendi, M.H., Tyasningsih, W., and Ugbo, E. N. 2022. Multidrug-resistant Salmonella species from chicken meat sold at Surabaya Traditional Markets, Indonesia. Biodiversitas, 23(6), 2823–2829. Gach, M.W., Lazarus, G., Simadibrata, D.M., Sinto, R., Saharman, Y.R., Limato, R., Nelwan, E.J., van Doorn, H.R., Karuniawati, A. and Hamers, R.L. 2024. Antimicrobial resistance among common bacterial pathogens in Indonesia: a systematic review. Lancet Reg. Health Southeast Asia 26(1), 100414. Galán-Relaño, á., Díaz, A.V., Lorenzo, B.H., Gómez- Gascón, L., Rodríguez, M.á.M., Jiménez, E.C., Rodríguez, F.P. and Márquez, R.J.A. 2023. Salmonella and salmonellosis: an update on public health implications and control strategies. Animals 13(23), 3666. Garai, P., Gnanadhas, D.P. and Chakravortty, D. 2012. Salmonella enterica serovars Typhimurium and Typhi as model organisms: revealing paradigm of host-pathogen interactions. Virulence 3(4), 377–388. Gil-Molino, M., GonÇalves, P., Risco, D., Martín-Cano, F.E., García, A., Rey, J., Fernández-Llario, P. and Quesada, A. 2022. Dissemination of antimicrobial- resistant isolates of Salmonella spp. in wild boars and its relationship with management practices. Transbound. Emerg. Dis. 69(5), e1488–e1502. Groisman, E.A., Hollands, K., Kriner, M.A., Lee, E.J., Park, S.Y. and Pontes, M.H. 2013. Bacterial Mg2+ homeostasis, transport, and virulence. Annu. Rev. Genet. 47(1), 625–646. Hai, D., Yin, X., Lu, Z., Lv, F., Zhao, H. and Bie, X. 2020. Occurrence, drug resistance, and virulence genes of Salmonella isolated from chicken and eggs. Food Control 113(1), 107109. Islam, K.N., Eshaa, E., Hassan, M., Chowdhury, T. and Zaman, S.U. 2022. Antibiotic susceptibility pattern and identification of multidrug-resistant novel Salmonella strain in poultry chickens of Hathazari region in Chattogram, Bangladesh. Adv. Microbiol. 12(2), 53–66. Jibril, A.H., Okeke, I.N., Dalsgaard, A., Kudirkiene, E., Akinlabi, O.C., Bello, M.B. and Olsen, J.E. 2020. Prevalence and risk factors of Salmonella in commercial poultry farms in Nigeria. PLoS One 15(9), e0238190. Kendek, I.A., Putri, M.F.R., Wibisono, F.J., Effendi, M.H., Tyasningsih, W., Ugbo, E.N. and Agumah, N.B. 2024. Molecular detection of hlyF gene on multidrug resistance of avian pathogenic Escherichia coli isolated from ducks on wet markets of Surabaya, Indonesia. Biodiversitas 25(3), 1246–1253. Khairullah, A.R., Kurniawan, S.C., Sudjarwo, S.A., Effendi, M.H., Afnani, D.A., Silaen, O.S.M., Putra, G.D.S., Riwu, K.H.P., Widodo, A. and Ramandinianto, S.C. 2023. Detection of multidrug- resistant Staphylococcus aureus and coagulase- negative staphylococci in cow milk and hands of farmers in East Java, Indonesia. Biodiversitas 24(1), 658–664. Khairullah, A.R., Kurniawan, S.C., Sudjarwo, S.A., Effendi, M.H., Widodo, A., Moses, I.B., Hasib, A., Zahra, R.L.A., Gelolodo, M.A., Kurniawati, D.A., Riwu, K.H.P., Silaen, O.S.M., Afnani, D.A. and Ramandinianto, S.C. 2024. Kinship analysis of mecA gene of methicillin-resistant Staphylococcus aureus isolated from milk and risk factors from the farmers in Blitar, Indonesia. Vet. World 17(1), 216–225. Khairullah, A.R., Raharjo, D., Rahmahani, J., Suwarno, Tyasningsih, W. and Harijani, N. 2019. Antibiotics resistant at Staphylococcus aureus and Streptococcus sp isolated from bovine mastitis in Karangploso, East Java, Indonesia. Indian J. Forensic Med. Toxicol. 13(4), 439–444. Kurtz, J.R., Goggins, J.A. and McLachlan, J.B. 2017. Salmonella infection: Interplay between the bacteria and host immune system. Immunol. Lett. 190(1), 42–50. Lamichhane, B., Mawad, A.M.M., Saleh, M., Kelley, W.G., Harrington, P.J., Lovestad, C.W., Amezcua, J., Sarhan, M.M., El Zowalaty, M.E., Ramadan, H., Morgan, M. and Helmy, Y.A. 2024. Salmonellosis: an overview of epidemiology, pathogenesis, and innovative approaches to mitigate the antimicrobial resistant infections. Antibiotics 13(1), 76. Lee, E.J., Pontes, M.H. and Groisman, E.A. 2013. A bacterial virulence protein promotes pathogenicity by inhibiting the bacterium’s own F1Fo ATP synthase. Cell 154(1), 146–156. Long, M., Yu, H., Chen, L., Wu, G., Zhao, S., Deng, W., Chen, S., Zhou, K., Liu, S., He, L., Ao, X., Yan, Y., Ma, M., Wang, H., Davis, M.A., Jones, L., Li, B., Zhang, A. and Zou, L. 2017. Recovery of Salmonella isolated from eggs and the commercial layer farms. Gut Pathog. 9(1), 74. Maharjan, A., Dhungel, B., Bastola, A., Shrestha, U.T., Adhikari, N., Banjara, M.R., Lekhak, B., Ghimire, P. and Rijal, K.R. 2021. Antimicrobial susceptibility pattern of Salmonella spp. isolated from enteric fever patients in Nepal. Infect. Dis. Rep. 13(2), 388–400. Mancuso, G., Midiri, A., Gerace, E. and Biondo, C. 2021. Bacterial antibiotic resistance: the most critical pathogens. Pathogens 10(10), 1310. Manyi-Loh, C., Mamphweli, S., Meyer, E. and Okoh, A. 2018. Antibiotic use in agriculture and its consequential resistance in environmental sources: potential public health implications. Molecules 23(4), 795. Marchello, C.S., Carr, S.D. and Crump, J.A. 2020. A systematic review on antimicrobial resistance among Salmonella typhi worldwide. Am. J. Trop. Med. Hyg. 103(6), 2518–2527. McMullin, P. 2022. Infectious diseases in free-range compared to conventional poultry production. Avian Pathol. 51(5), 424–434. Mir, N.A., Rafiq, A., Kumar, F., Singh, V. and Shukla, V. 2017. Determinants of broiler chicken meat quality and factors affecting them: a review. J. Food Sci. Technol. 54(10), 2997–3009. Mkangara, M. 2023. Prevention and control of human Salmonella enterica infections: an implication in food safety. Int. J. Food Sci. 2023(1), 8899596. Momani, W.A., Khatatbeh, M.M. and Janakat, S. 2018. Bacterial contamination of table eggs sold in Jordanian markets. Pak. J. Nutr. 17(1), 15–20. Moncrief, M.B. and Maguire, M.E. 1998. Magnesium and the role of mgtC in growth of Salmonella typhimurium. Infect. Immun. 66(8), 3802–3809. Nair, D.V.T., Venkitanarayanan, K. and Johny, A.K. 2018. Antibiotic-resistant salmonella in the food supply and the potential role of antibiotic alternatives for control. Foods 7(10), 167. Neelawala, R.N., Edison, L.K. and Kariyawasam, S. 2024. Pre-harvest non-typhoidal Salmonella control strategies in commercial layer chickens. Animals 14(24), 3578. Olabode, V.B., Barde, I.J., Shekaro, A., Benson, M.N., Idachaba, S.E., Oguche, M.O., Agada, G.O. and Dashe, Y.G. 2020. Occurrence and characterization of Salmonella isolates in raw eggs from quail and chicken in selected poultry farms in Jos, Plateau State, Nigeria. J. Vet. Med. Anim. Health 12(3), 132–138. Oladeinde, A., Abdo, Z., Press, M.O., Cook, K., Cox, N.A., Zwirzitz, B., Woyda, R., Lakin, S.M., Thomas, J.C. 4th, Looft, T., Cosby, D.E., Hinton, A. Jr., Guard, J., Line, E., Rothrock, M.J., Berrang, M.E., Herrington, K., Zock, G., Lawrence, J.P., Cudnik, D., House, S., Ingram, K., Lariscy, L., Wagner, M., Aggrey, S.E., Chai, L. and Ritz, C. 2021. Horizontal gene transfer is the main driver of antimicrobial resistance in broiler chicks infected with Salmonella enterica Serovar Heidelberg. mSystems 6(4), e0072921. Perry, J.J. and Yousef, A.E. 2012. Salmonella enteritidis in shell eggs: evolving concerns and innovative control measures. Adv. Appl. Microbiol. 81(1), 243–274. Pławińska-Czarnak, J., Wódz, K., Kizerwetter- Świda, M., Bogdan, J., Kwieciński, P., Nowak, T., Strzałkowska, Z. and Anusz, K. 2022. Multi-drug resistance to Salmonella spp. when isolated from raw meat products. Antibiotics (Basel, Switzerland) 11(7), 876. Pradika, A.Y., Chusniati, S., Purnama, M.T.E., Effendi, M.H., Yudhana, A. and Wibawati, P.A. 2019. Total Test of Escherichia coli on fresh cow milk at dairy farmer cooperative (KPSP) Karyo Ngremboko Purwoharjo Banyuwangi. J. Med. Vet. 2(1), 1–6. Promega. 2018. Certificate of analysis gotaq green master mix. Madison, WI: Promega. Puglisi, M.J. and Fernandez, M.L. 2022. The health benefits of egg protein. Nutrients 14(14), 2904. Putri, M.F.R., Kendek, I.A., Wibisono, F.J., Effendi, M.H., Rahardjo, D., Tyasningsih, W. and Ugbo, E.N. 2023. Molecular detection of iron gene on multidrug resistant avian fecal Escherichia coli isolated from broiler on traditional markets, Surabaya, Indonesia. Biodiversitas 24(12), 6454–6460. Putri, M.F.R., Khairullah, A.R., Effendi, M.H., Wibisono, F.J., Hasib, A., Moses, I.B., Fauziah, I., Kusala, M.K.J., Raissa, R. and Yanestria, S.M. 2024. Detection of the CTX-M gene associated with extended-spectrum β-lactamase (ESBL) in broiler chickens in surabaya traditional markets. J. Med. Vet. 7(2), 320–334. Ramandinianto, S.C., Khairullah, A.R., Effendi, M.H., Tyasningsih, W. and Rahmahani, J. 2020. Detection of enterotoxin type B gene on methicillin resistant Staphylococcus aureus (MRSA) isolated from raw milk in East Java, Indonesia. Sys. Rev. Pharm. 11(7), 290–298. Réhault-Godbert, S., Guyot, N. and Nys, Y. 2019. The golden egg: nutritional value, bioactivities, and emerging benefits for human health. Nutrients 11(3), 684. Rouger, A., Tresse, O. and Zagorec, M. 2017. bacterial contaminants of poultry meat: sources, species, and dynamics. Microorganisms 5(3), 50. Shaji, S., Selvaraj, R.K. and Shanmugasundaram, R. 2023. Salmonella infection in poultry: a review on the pathogen and control strategies. Microorganisms 11(11), 2814. Siriken, B., Al, G. and Erol, I. 2020. Prevalence and antibiotic resistance of salmonella enteritidis and salmonella typhimurium in ground beef and meatball samples in Samsun, Turkey. Microb. Drug Resist. 26(2), 136–144. Soria, M.A., Costa, A.T., Chichi, M., Bruno, S.B., Terragno, R., Tellez-Isaias, G. and Bueno, D.J. 2024. Salmonella spp. isolation from different types of egg samples and antimicrobial resistance of these strains in Argentina. Ger. J. Microbiol. 4(2), 54–66. Syafitri, M., Erina, M.D.A.K., Ferasyi, T.R., Hamzah, A., Nazaruddin, N. and Ismail, I. 2023. Resistance testing of Salmonella sp. isolated from broiler chicken against antibiotics. J. Med. Vet. 17(1), 15–22. Tao, H., Wang, J., Li, L., Zhang, H.Z., Chen, M.P. and Li, L. 2017. Incidence and antimicrobial sensitivity profiles of normal conjunctiva bacterial flora in the central area of China: a hospital-based study. Front. Physiol. 8(1), 363. Wahyuningsih, E., Sulistiyawati, I. and Zaenuri, M. 2019. Identification of Salmonella sp. in broiler egg sold in Pasar Wage Purwokerto for development of microbiology teaching materials. Bioedusiana 4(2), 79–83. Whiley, H. and Ross, K. 2015. Salmonella and eggs: from production to plate. Int. J. Environ. Res. Public Health 12(3), 2543–2556. Wibisono, F.M., Faridah, H.D., Wibisono, F.J., Tyasningsih, W., Effendi, M.H., Witaningrum, A.M. and Ugbo, E.N. 2021. Detection of invA virulence gene of multidrug-resistant Salmonella species isolated from the cloacal swab of broiler chickens in Blitar district East Java Indonesia. Vet. World 14(12), 3126–3131. Widodo, A., Lamid, M., Effendi, M.H., Khairullah, A.R., Riwu, K.H.P., Yustinasari, L.R., Kurniawan, S.C., Ansori, A.N.M., Silaen, O.S.M. and Dameanti, F.N.A.E.P. 2022. Antibiotic sensitivity profile of multidrug-resistant (MDR) Escherichia coli isolated from dairy cow’s milk in Probolinggo, Indonesia. Biodiversitas 23(10), 4971–4976. Widodo, A., Lamid, M., Effendi, M.H., Tyasningsih, W., Raharjo, D., Khairullah, A.R., Kurniawan, S.C., Yustinasari, L.R., Riwu, K.H.P. and Silaen, O.S.M. 2023. Molecular identification of blaTEM and blaCTX-M genes in multidrug-resistant Escherichia coli found in milk samples from dairy cattle farms in Tulungagung, Indonesia. J. Vet. Res. 67(3), 381–388. Yousuf, S., Karlinsey, J.E., Neville, S.L., McDevitt, C.A., Libby, S.J., Fang, F.C. and Frawley, E.R. 2020. Manganese import protects Salmonella enterica serovar Typhimurium against nitrosative stress. Metallomics 12(11), 1791–1801. Yulian, R., Narulita, E., Iqbal, M., Sari, D.R., Suryaningsih, I. and Ningrum, D.E.A.F. 2020. Detection of virulence and specific genes of Salmonella sp. indigenous from Jember, Indonesia. Biodiversitas 21(7), 2889–2892. | ||
| How to Cite this Article |
| Pubmed Style Srimaryanto LR, Tyasningsih W, Sulaiman AA, Budiastuti B, Khairullah AR, Effendi MH, Kurniasari P, Widodo A, Yanestria SM, Moses IB, Ahmad RZ, Riwu KHP, Afnani DA, Rehman S. Detection of the mgtC gene in multidrug-resistant Salmonella sp. based on isolation of chicken eggshell swabs from traditional Surabaya markets. Open Vet. J.. 2025; 15(6): 2661-2670. doi:10.5455/OVJ.2025.v15.i6.35 Web Style Srimaryanto LR, Tyasningsih W, Sulaiman AA, Budiastuti B, Khairullah AR, Effendi MH, Kurniasari P, Widodo A, Yanestria SM, Moses IB, Ahmad RZ, Riwu KHP, Afnani DA, Rehman S. Detection of the mgtC gene in multidrug-resistant Salmonella sp. based on isolation of chicken eggshell swabs from traditional Surabaya markets. https://www.openveterinaryjournal.com/?mno=244311 [Access: January 24, 2026]. doi:10.5455/OVJ.2025.v15.i6.35 AMA (American Medical Association) Style Srimaryanto LR, Tyasningsih W, Sulaiman AA, Budiastuti B, Khairullah AR, Effendi MH, Kurniasari P, Widodo A, Yanestria SM, Moses IB, Ahmad RZ, Riwu KHP, Afnani DA, Rehman S. Detection of the mgtC gene in multidrug-resistant Salmonella sp. based on isolation of chicken eggshell swabs from traditional Surabaya markets. Open Vet. J.. 2025; 15(6): 2661-2670. doi:10.5455/OVJ.2025.v15.i6.35 Vancouver/ICMJE Style Srimaryanto LR, Tyasningsih W, Sulaiman AA, Budiastuti B, Khairullah AR, Effendi MH, Kurniasari P, Widodo A, Yanestria SM, Moses IB, Ahmad RZ, Riwu KHP, Afnani DA, Rehman S. Detection of the mgtC gene in multidrug-resistant Salmonella sp. based on isolation of chicken eggshell swabs from traditional Surabaya markets. Open Vet. J.. (2025), [cited January 24, 2026]; 15(6): 2661-2670. doi:10.5455/OVJ.2025.v15.i6.35 Harvard Style Srimaryanto, L. R., Tyasningsih, . W., Sulaiman, . A. A., Budiastuti, . B., Khairullah, . A. R., Effendi, . M. H., Kurniasari, . P., Widodo, . A., Yanestria, . S. M., Moses, . I. B., Ahmad, . R. Z., Riwu, . K. H. P., Afnani, . D. A. & Rehman, . S. (2025) Detection of the mgtC gene in multidrug-resistant Salmonella sp. based on isolation of chicken eggshell swabs from traditional Surabaya markets. Open Vet. J., 15 (6), 2661-2670. doi:10.5455/OVJ.2025.v15.i6.35 Turabian Style Srimaryanto, Leonardo Reza, Wiwiek Tyasningsih, Azhari Athaillah Sulaiman, Budiastuti Budiastuti, Aswin Rafif Khairullah, Mustofa Helmi Effendi, Pitaloka Kurniasari, Agus Widodo, Sheila Marty Yanestria, Ikechukwu Benjamin Moses, Riza Zainuddin Ahmad, Katty Hendriana Priscilia Riwu, Daniah Ashri Afnani, and Saifur Rehman. 2025. Detection of the mgtC gene in multidrug-resistant Salmonella sp. based on isolation of chicken eggshell swabs from traditional Surabaya markets. Open Veterinary Journal, 15 (6), 2661-2670. doi:10.5455/OVJ.2025.v15.i6.35 Chicago Style Srimaryanto, Leonardo Reza, Wiwiek Tyasningsih, Azhari Athaillah Sulaiman, Budiastuti Budiastuti, Aswin Rafif Khairullah, Mustofa Helmi Effendi, Pitaloka Kurniasari, Agus Widodo, Sheila Marty Yanestria, Ikechukwu Benjamin Moses, Riza Zainuddin Ahmad, Katty Hendriana Priscilia Riwu, Daniah Ashri Afnani, and Saifur Rehman. "Detection of the mgtC gene in multidrug-resistant Salmonella sp. based on isolation of chicken eggshell swabs from traditional Surabaya markets." Open Veterinary Journal 15 (2025), 2661-2670. doi:10.5455/OVJ.2025.v15.i6.35 MLA (The Modern Language Association) Style Srimaryanto, Leonardo Reza, Wiwiek Tyasningsih, Azhari Athaillah Sulaiman, Budiastuti Budiastuti, Aswin Rafif Khairullah, Mustofa Helmi Effendi, Pitaloka Kurniasari, Agus Widodo, Sheila Marty Yanestria, Ikechukwu Benjamin Moses, Riza Zainuddin Ahmad, Katty Hendriana Priscilia Riwu, Daniah Ashri Afnani, and Saifur Rehman. "Detection of the mgtC gene in multidrug-resistant Salmonella sp. based on isolation of chicken eggshell swabs from traditional Surabaya markets." Open Veterinary Journal 15.6 (2025), 2661-2670. Print. doi:10.5455/OVJ.2025.v15.i6.35 APA (American Psychological Association) Style Srimaryanto, L. R., Tyasningsih, . W., Sulaiman, . A. A., Budiastuti, . B., Khairullah, . A. R., Effendi, . M. H., Kurniasari, . P., Widodo, . A., Yanestria, . S. M., Moses, . I. B., Ahmad, . R. Z., Riwu, . K. H. P., Afnani, . D. A. & Rehman, . S. (2025) Detection of the mgtC gene in multidrug-resistant Salmonella sp. based on isolation of chicken eggshell swabs from traditional Surabaya markets. Open Veterinary Journal, 15 (6), 2661-2670. doi:10.5455/OVJ.2025.v15.i6.35 |